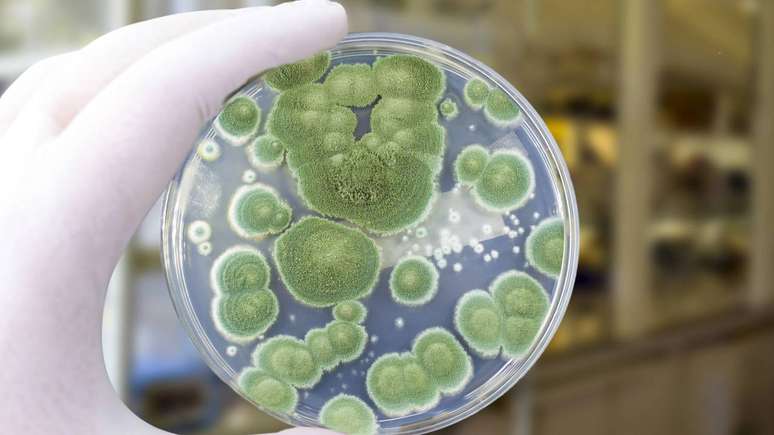
O respons&aacute;vel pela descoberta da penicilina foi um fungo microsc&oacute;pico produtor de mofo, pertencente ao g&ecirc;nero Penicillium &ndash; depositphotos.com / katerynakon

O cogumelo que virou super-herói: como Fleming descobriu a penicilina
A história da penicilina costuma ser contada como a descoberta de um "remédio milagroso". Saiba como ela surgiu.
A história da penicilina costuma ser contada como a descoberta de um "remédio milagroso". Porém, na prática, envolveu acaso, observação cuidadosa e um fungo bem específico. A pergunta sobre se um cogumelo deu início à penicilina parte de uma confusão comum entre diferentes tipos de fungos. O que se sabe hoje é que a penicilina nasceu da ação de um fungo microscópico, e não de um cogumelo no sentido popular do termo, embora ambos pertençam ao grande reino dos fungos.
O ponto central dessa história é a capacidade de certos microrganismos de produzir substâncias capazes de inibir ou matar bactérias. Ao longo das décadas, pesquisas mostraram que fungos, bactérias e outros seres microscópicos travam uma verdadeira disputa por espaço e nutrientes, usando compostos químicos como arma. A penicilina é um desses compostos. Por isso, entender se um "cogumelo" deu origem a esse antibiótico exige diferenciar o fungo que o produz dos cogumelos visíveis a olho nu encontrados em florestas ou mercados.
Penicilina: fungo, cogumelo ou outra coisa?
A palavra-chave nesse tema é penicilina, nome dado a um grupo de antibióticos derivados de fungos do gênero Penicillium. Afinal, esses fungos não formam cogumelos grandes e carnosos, mas colônias de aparência aveludada ou esverdeada, comuns em alimentos estragados, paredes úmidas e materiais orgânicos em decomposição. Do ponto de vista biológico, são fungos filamentosos, distintos dos cogumelos clássicos, embora todos sejam fungos.
Em termos populares, o termo "cogumelo" reserva-se aos fungos que produzem estruturas visíveis, com "chapéu" e "haste", como os usados na culinária. Já o fungo que originou a penicilina é microscópico e cresce como mofo. Assim, dizer que um cogumelo deu início à penicilina não é tecnicamente preciso. O que deu origem ao antibiótico foi um mofo do gênero Penicillium, mais especificamente linhagens relacionadas a Penicillium notatum e, depois, Penicillium chrysogenum.
Como surgiu a penicilina na prática?
A descoberta da penicilina deve-se ao trabalho de Alexander Fleming, em 1928, em um laboratório em Londres. Durante experimentos com bactérias, ele observou que uma placa de cultura havia sido contaminada por um fungo. Ao invés de descartar o material, analisou o que estava acontecendo. Notou que, ao redor do fungo, as bactérias não cresciam. Esse "halo" sem bactérias indicava que o fungo produzia uma substância capaz de inibi-las.
Essa substância passou a ser chamada de penicilina. Anos mais tarde, outros pesquisadores, como Howard Florey, Ernst Chain e equipes de diferentes países, trabalharam para isolar, purificar e produzir o composto em maior escala. O desenvolvimento industrial da penicilina, especialmente durante a Segunda Guerra Mundial, permitiu o uso amplo do antibiótico em hospitais. Assim, foi nesse período que a molécula passou a ser vista como um marco no tratamento de infecções bacterianas.
O processo de produção moderna envolve o cultivo controlado de fungos em biorreatores, com nutrientes específicos, oxigenação e temperatura regulada. Durante esse crescimento, o fungo libera a penicilina no meio. Depois, o antibiótico é extraído, purificado e transformado em diferentes formas farmacêuticas, como comprimidos, cápsulas e soluções injetáveis. Todo esse caminho começou com a observação de um simples mofo em uma placa de laboratório, e não com um cogumelo visível.
Então é verdade que um cogumelo deu início à penicilina?
Do ponto de vista científico, a afirmação de que um cogumelo deu início à penicilina não é exata. O responsável foi um fungo microscópico produtor de mofo, pertencente ao gênero Penicillium. Embora cogumelos e esse fungo sejam parentes no reino dos fungos, tratam-se de organismos com formas e estruturas bem diferentes. A confusão surge porque, em linguagem informal, qualquer fungo pode ser chamado de "cogumelo" ou "bolor", o que não corresponde à classificação biológica.
Para resumir a relação entre fungo e penicilina, é possível destacar alguns pontos:
- A penicilina é produzida por fungos do gênero Penicillium, que formam mofo, não cogumelos típicos.
- Cogumelos culinários, como champignon ou shiitake, pertencem a outros grupos de fungos, sem ligação direta com a penicilina.
- Apesar dessa diferença, todos esses organismos fazem parte do mesmo reino biológico, o que explica algumas semelhanças gerais.
Qual é a importância dessa descoberta até hoje?
Mesmo quase um século depois da primeira observação do mofo que originou a penicilina, o impacto dessa descoberta continua evidente. A penicilina e seus derivados fizeram parte da base do tratamento de inúmeras infecções bacterianas, como pneumonias, amigdalites bacterianas e infecções de pele. Além disso, abriram caminho para outros antibióticos, estimulando a busca por substâncias semelhantes em diferentes microrganismos.
Ao mesmo tempo, o uso amplo e, em algumas situações, inadequado de antibióticos contribuiu para o surgimento de bactérias resistentes. Esse fenômeno levou pesquisadores a repensar estratégias de prescrição e a buscar novos compostos antimicrobianos. Assim, a história da penicilina não se limita ao passado: ela continua ligada aos debates atuais sobre resistência bacteriana, uso racional de medicamentos e desenvolvimento de novas terapias.
Em síntese, a origem da penicilina está em um fungo microscópico e em uma sequência de observações e estudos que transformaram um simples mofo em um dos medicamentos mais importantes da história da medicina. A ideia de que um cogumelo deu início a tudo simplifica em excesso o processo, mas ajuda a destacar um ponto central: pequenos organismos podem ter papel decisivo na saúde humana quando estudados com atenção e método científico.

-trqtkdhuzzvm.jpg)








-(1)-1ibea6sih6x4n.png)

Comentários
Os comentários são de responsabilidade exclusiva de seus autores e não representam a opinião deste site. Se achar algo que viole os termos de uso, denuncie.